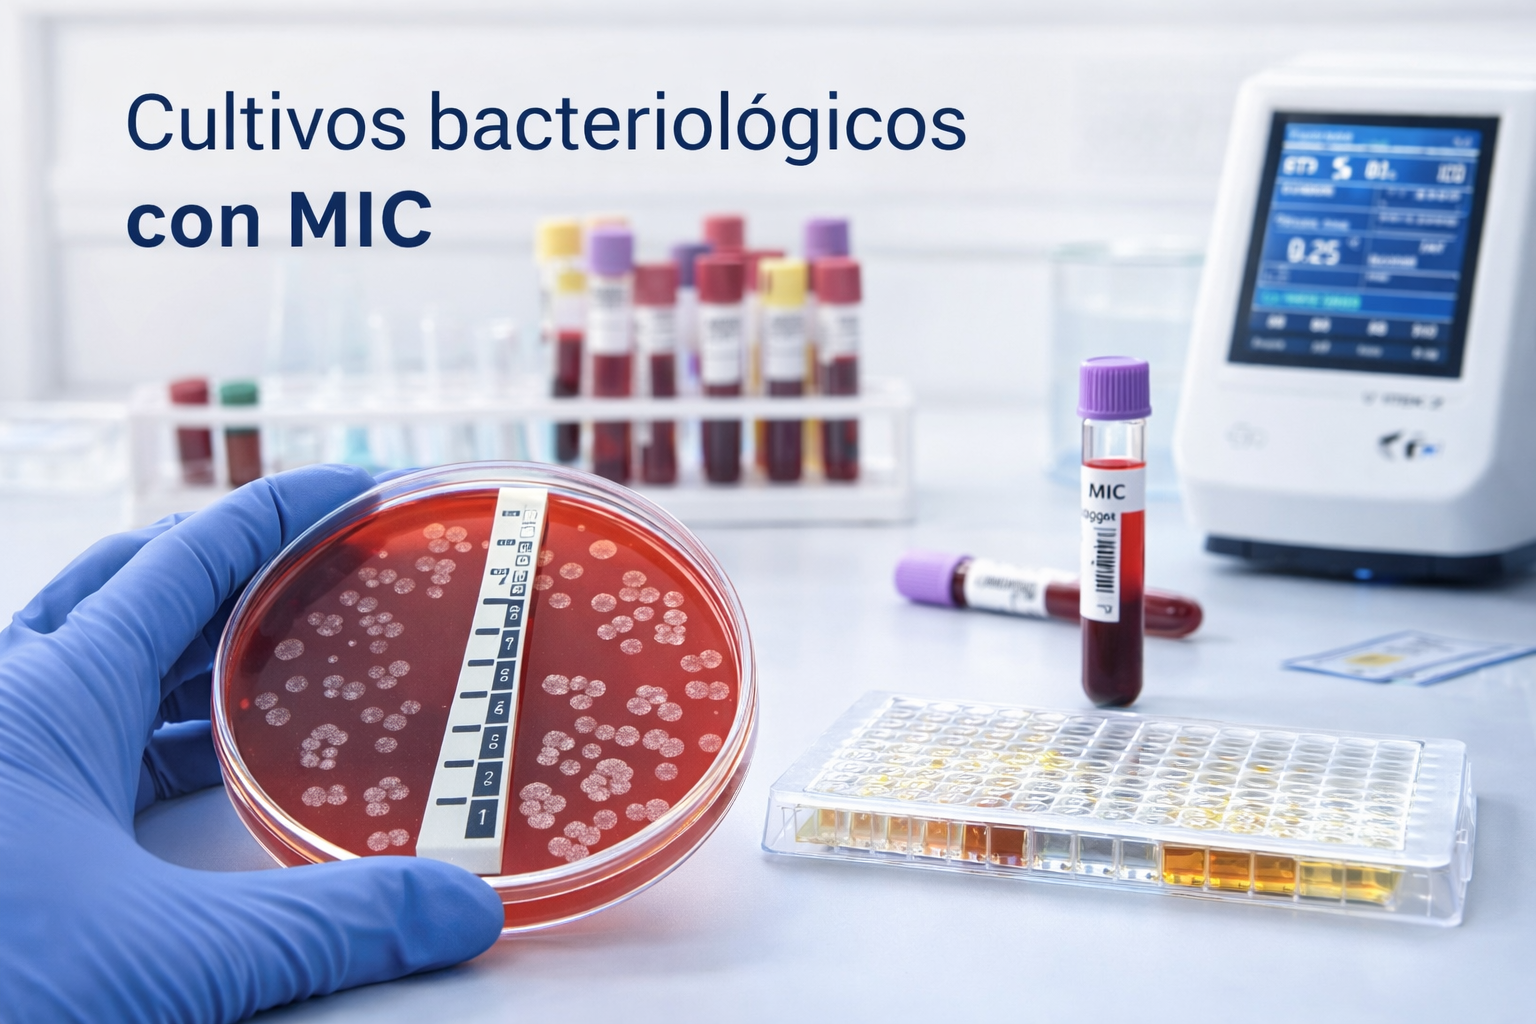

Laboratorio clínico de alta precisión
Diagnóstico clínico de alta precisión y confianza real
En Biodiagnóstico López combinamos procesos confiables, tecnología avanzada y atención profesional para brindarte resultados oportunos y claros.
Diagnósticos confiables para tu tranquilidad
Indicadores de confianza
Estudios más solicitados
Conoce algunos de los estudios clínicos más solicitados por nuestros pacientes.

Perfil principal de salud
Evaluación integral del estado de salud que incluye biometría hemática, química sanguínea de 6 elementos, evaluación de función renal (BUN y TEFG) y examen general de orina.

Biometría hemática completa
Análisis hematológico que evalúa glóbulos rojos, glóbulos blancos y plaquetas para detectar anemia, infecciones y otras alteraciones de la sangre.

Examen general de orina
Análisis de orina que ayuda a detectar infecciones urinarias, problemas renales y alteraciones metabólicas.

Perfil metabólico básico
Análisis que evalúa glucosa, colesterol y triglicéridos para valorar el metabolismo y el riesgo de enfermedades cardiovasculares.

Hemoglobina glicada
Evalúa el promedio de glucosa en sangre de los últimos 3 meses, siendo uno de los estudios más importantes para diagnóstico y control de diabetes.
Cultivos bacteriológicos con MIC
Identificamos bacterias causantes de infección y evaluamos su sensibilidad a antibióticos mediante Concentración Mínima Inhibitoria (MIC).
¿Por qué elegirnos?
Confianza y precisión en cada resultado
Resultados confiables
Procesos analíticos controlados y verificados para garantizar resultados precisos y confiables en cada estudio.
Resultados el mismo día
La mayoría de nuestros estudios se entregan el mismo día para que puedas tomar decisiones médicas oportunas.
Tecnología automatizada
Equipos automatizados y tecnología moderna que aseguran exactitud en cada análisis clínico.
Atención profesional
Personal capacitado que te acompañará durante todo el proceso con atención clara y profesional.
Amplio catálogo de estudios
Desde estudios básicos hasta perfiles especializados para el seguimiento integral de tu salud.
Resultados en línea
Consulta tus resultados desde cualquier lugar de forma segura a través de nuestro portal digital.
Servicios para empresas
Soluciones de diagnóstico clínico para empresas, instituciones y programas de salud ocupacional.
Convenios para empresas
En Biodiagnóstico López ofrecemos convenios empresariales para programas de salud ocupacional, evaluaciones médicas laborales y perfiles clínicos para ingreso o seguimiento del personal.
Nuestro equipo te ayudará a diseñar un esquema de estudios adaptado a las necesidades de tu empresa con resultados confiables y tiempos de respuesta rápidos.
- Exámenes médicos de ingreso laboral
- Evaluaciónes periódicas para personal
- Perfiles clínicos empresariales
- Resultados rápidos y confiables
